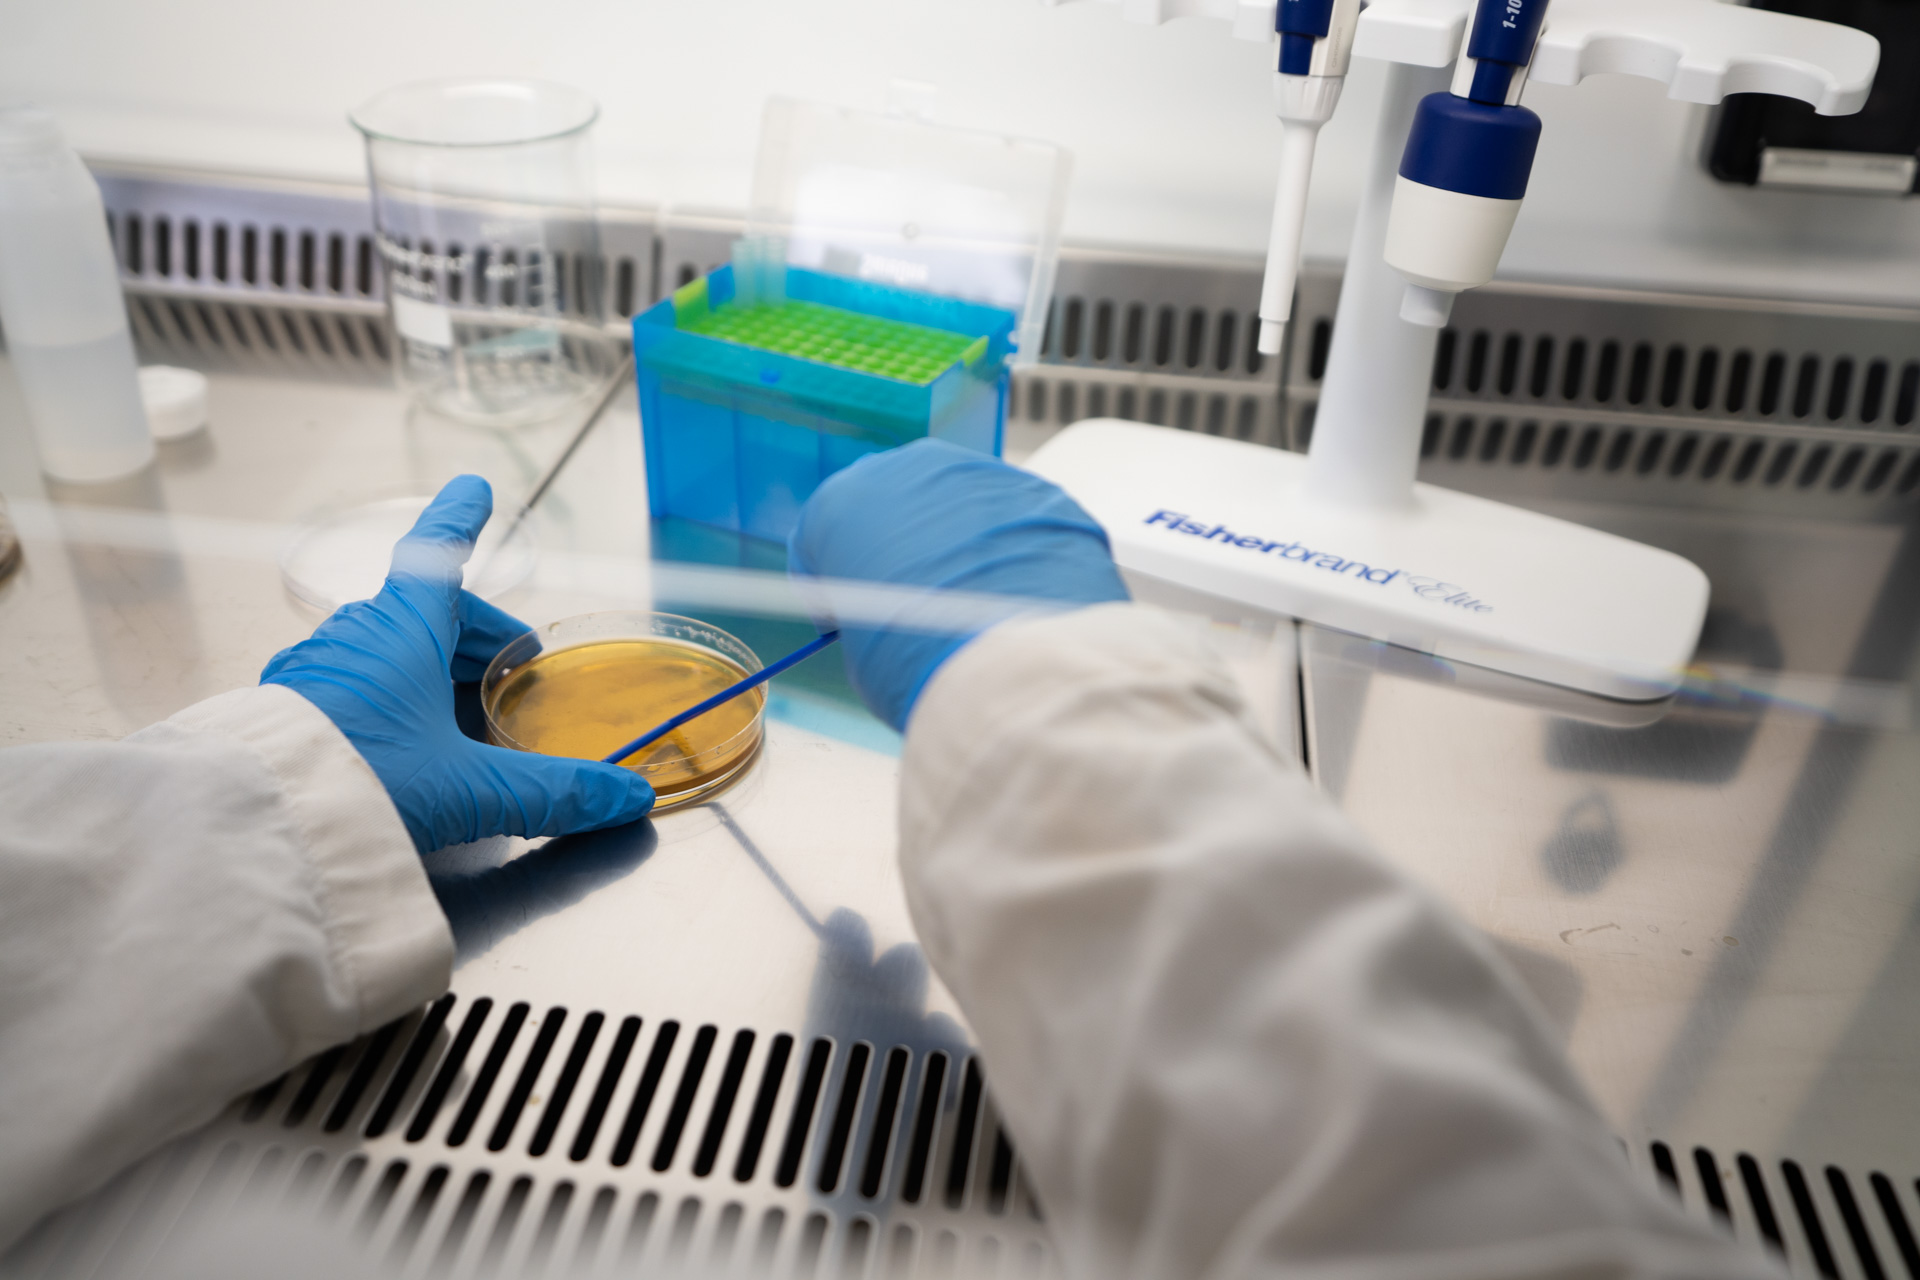
Laboratoire Toopi Organics

Qui sommes-nous ?
Une production de solutions organiques au plus proche des utilisateurs
Notre site de production

Notre site de production en Nouvelle-Aquitaine
C'est en Gironde, au coeur de la Nouvelle-Aquitaine, qu'on fabrique nos solutions. Nos installations sont conçues pour garantir la qualité et la traçabilité de chaque lot, de la matière première jusqu'au conditionnement final. Chaque cuve, chaque étape de fermentation est contrôlée pour que vous receviez toujours le même produit, avec la même efficacité.

Développement en Belgique
Le développement de nos solutions en Belgique s'appuie sur un partenariat solide avec la SCAM, Coopérative Agricole de la Meuse. Grâce à cette collaboration étroite avec les équipes de la coopérative et les agriculteurs locaux, nous avons pu déployer nos produits dans des conditions réelles d'utilisation et les adapter aux besoins du terrain. Depuis plusieurs années, les agriculteurs membres de la SCAM utilisent nos solutions et constatent leurs bénéfices au quotidien.
Notre équipe

Collecte
Collecte et approvisionnement en matières premières naturelles
R&D
Recherche et développement de nouvelles formulations
Agronomie
Suivi terrain et conseil aux agriculteurs
Production
Fabrication et contrôle qualité des solutions
Commercial
Développement des partenariats et distribution
Quelques chiffres clés
Chaque litre d'urine collecté évite du gaspillage, préserve l'eau potable et protège nos systèmes naturels.
Notre technologie brevetée
Cultiver des actifs biologiques
Notre procédé industriel permet d'assainir la matière première, notamment en éliminant les métaux lourds et autres composés indésirables. Cette transformation crée un milieu de culture adapté au développement de bactéries d'intérêt agronomique.
Traçabilité et reproductibilité
Chaque lot suit un protocole strict. Même composition, même efficacité, saison après saison. La traçabilité est totale, de la matière première jusqu'au bidon qui arrive chez vous. Ce n'est pas juste une promesse — c'est inscrit dans notre process de fabrication.
Nos valeurs
Curiosité
Guidés par la curiosité, nous approfondissons notre compréhension des sols, des plantes et des micro-organismes afin de proposer des solutions toujours plus efficaces et adaptées au terrain.
Ambition
Nous sommes convaincus qu'un retour à une agriculture préservatrice est possible. Notre objectif est d'offrir aux agriculteurs des alternatives aux intrants chimiques, sans compromis sur la performance agronomique.
Bienveillance
La bienveillance guide nos actions, surtout entre nous au sein de l'équipe, plus qu'un mot, une manière concrète de travailler.
Une question ? Parlons-en.
Notre équipe est disponible pour répondre à vos questions agronomiques ou commerciales.
Nous contacter